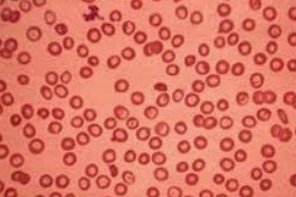

احنا قلنا 4 سلاسل صح ؟
الحين بنتعرف اكثر على انواع القصور او الخلل و شنو ينتج عنه:
- عند حدوث خلل في سلسلة واحدة = يعد الشخص حاملاً للجين المصاب و بلا اعراض ظاهرة
الحين بنتعرف اكثر على انواع القصور او الخلل و شنو ينتج عنه:
- عند حدوث خلل في سلسلة واحدة = يعد الشخص حاملاً للجين المصاب و بلا اعراض ظاهرة
عند حدوث خلل في ثلاث سلاسل :
يكون هناك فقر دم شديد و تتراوح الاعراض بين المتوسطة والشديدة و قد يصاب المريض بتضخم الطحال و تشوه في العظام
يكون هناك فقر دم شديد و تتراوح الاعراض بين المتوسطة والشديدة و قد يصاب المريض بتضخم الطحال و تشوه في العظام
عند حدوث خلل في اربع سلاسل :
يتسبب في وفاة الجنين قبل الولادة او بعد الولادة مباشرة.
وهذه حالة نادرة الحدوث ان يحدث خلل في السلاسل الاربعة
يتسبب في وفاة الجنين قبل الولادة او بعد الولادة مباشرة.
وهذه حالة نادرة الحدوث ان يحدث خلل في السلاسل الاربعة
النوع الثاني هو عند حدوث خلل في سلسلتين و تسمى الحالة بـ " الثلاسيميا الكبرى" و هي الوجه الاخطر للمرض و تبدأ الاعراض بالظهور مع مرحلة الطفولة و يحتاج ان يتزود المريض بالدم بين فترات قصيرة.
كما ان المرضى يصابون بتضخم الطحال نتيجة لنقل الدم المستمر و تكدس كمية من الحديد
#يتبع
كما ان المرضى يصابون بتضخم الطحال نتيجة لنقل الدم المستمر و تكدس كمية من الحديد
#يتبع
النوع الثالث يسمى بـ ثلاسيميا بيتا المتوسطة
وهي حالة وسط بين نوعي ثلاسيميا الكبرى و الصغرى، حيث يستطيع الاشخاص المصابون بها العيش حياه شبه طبيعية، الا انهم قد يحتاجون الى نقل دم في اوقات المرض او الحمل.
وهي حالة وسط بين نوعي ثلاسيميا الكبرى و الصغرى، حيث يستطيع الاشخاص المصابون بها العيش حياه شبه طبيعية، الا انهم قد يحتاجون الى نقل دم في اوقات المرض او الحمل.
عوامل الخطر :
- التاريخ العائلي للاصابة بالثلاسيميا
- سلالات معينة اكثر عرضه من غيرهم للاصابة بالمرض مثل الامريكيون الافارقة و المنحدرون من البحر المتوسط و جنوب شرق اسيا
للوقاية :
ينصح بإجراء الفحص الطبي الشامل قبل الزواج.
- التاريخ العائلي للاصابة بالثلاسيميا
- سلالات معينة اكثر عرضه من غيرهم للاصابة بالمرض مثل الامريكيون الافارقة و المنحدرون من البحر المتوسط و جنوب شرق اسيا
للوقاية :
ينصح بإجراء الفحص الطبي الشامل قبل الزواج.
2- تضخم الطحال
يساعد الطحال على مكافحة العدوى وترشيح المواد الغير مرغوب فيها مثل خلايا الدم التالفه.
و عادةً ما يصاحب مريض الثلاسيميا تدمير عدد كبير من خلايا الدم الحمراء وهذا يجعل الطحال يتضخم و يزيد سوء حالة فقر الدم و يقلص حياة خلايا الدم المنقولة.
و قد يقترح الطبيب ازالته
يساعد الطحال على مكافحة العدوى وترشيح المواد الغير مرغوب فيها مثل خلايا الدم التالفه.
و عادةً ما يصاحب مريض الثلاسيميا تدمير عدد كبير من خلايا الدم الحمراء وهذا يجعل الطحال يتضخم و يزيد سوء حالة فقر الدم و يقلص حياة خلايا الدم المنقولة.
و قد يقترح الطبيب ازالته
3- بطئ معدل النمو وتأخر البلوغ بسبب فقر الدم
4- مشكلات في القلب مثل فشل القلب الاحتقاني و اضطراب النظم القلبي
4- مشكلات في القلب مثل فشل القلب الاحتقاني و اضطراب النظم القلبي
العلاج :
علاج مرض الثلاسيميا يعتمد على نوع الثلاسيميا و شدته و يشمل ما يلي :
1- نقل الدم
نقل خلايا الدم الحمراء بطريقة متكررة هي العلاج الرئيسي للاشخاص الذين لديهم ثلاسيميا معتدلة او الشديدة
2- زرع الخلايا الجذعية "زرع نخاع العظام"
3- علاج تكدس الحديد
علاج مرض الثلاسيميا يعتمد على نوع الثلاسيميا و شدته و يشمل ما يلي :
1- نقل الدم
نقل خلايا الدم الحمراء بطريقة متكررة هي العلاج الرئيسي للاشخاص الذين لديهم ثلاسيميا معتدلة او الشديدة
2- زرع الخلايا الجذعية "زرع نخاع العظام"
3- علاج تكدس الحديد
ارشادات صحية للمصابين بالثلاسيميا:
1- تجنب تناول اقراص الحديد والفيتامينات بدون اشراف طبيب ❌
2- تناول غذاء صحي و متوازن ✔️
3- الحرص على القيام بعمل فحص دم بشكل روتيني للتأكد من نسبة الدم ✔️
4- الحرص على اخذ اللقاحات لمنع العدوى ✔️
1- تجنب تناول اقراص الحديد والفيتامينات بدون اشراف طبيب ❌
2- تناول غذاء صحي و متوازن ✔️
3- الحرص على القيام بعمل فحص دم بشكل روتيني للتأكد من نسبة الدم ✔️
4- الحرص على اخذ اللقاحات لمنع العدوى ✔️
من ويانا ؟ 😍👏🏼
هاا نكمل ولا تحسون وايد المعلومات 😂🤓
هاا نكمل ولا تحسون وايد المعلومات 😂🤓
اليوم بنتكلم عن النوعين المتبقيين من الثلاسيميا وهم :
- دلتا ثلاسيميا
- اعتلالات الهيموغلوبين
- دلتا ثلاسيميا
- اعتلالات الهيموغلوبين
دلتا ثلاسيميا:
هو اضطراب في الهيموغلوبين و مثل ما قلنا ان الهيموغلوبين مكون رئيسي لخلايا الدم الحمراء و هو مرض وراثي يحدث نتيجة انخفاض انتاج مكونين من جزيء الهيموغلوبين و هم سلاسل بيتا و غاما.
فـ نتيجة لوجود انخفاض في هالسلسلتين يكون في تعويض وهالتعويض يكون
#يتبع
هو اضطراب في الهيموغلوبين و مثل ما قلنا ان الهيموغلوبين مكون رئيسي لخلايا الدم الحمراء و هو مرض وراثي يحدث نتيجة انخفاض انتاج مكونين من جزيء الهيموغلوبين و هم سلاسل بيتا و غاما.
فـ نتيجة لوجود انخفاض في هالسلسلتين يكون في تعويض وهالتعويض يكون
#يتبع
- في حال ان اصابة احد الوالدين بـ بيتا ثلاسيميا و انجاب طفل يحمل دلتا ثلاسيميا فـ سيعاني من فقر الدم من النوع المتوسط للثلاسيميا ، و هو شكل معتدل من المرض
- في حال نقل جين الثلاسيميا من كلا الوالدين و انجاب طفل يحمل دلتا ثلاسيميا فـ سيكون مصاباً بفقر الدم الرئيسي
#يتبع
- في حال نقل جين الثلاسيميا من كلا الوالدين و انجاب طفل يحمل دلتا ثلاسيميا فـ سيكون مصاباً بفقر الدم الرئيسي
#يتبع
الثلاسيميا الكبرى تتشابه ويا البيتا ثلاسيميا الكبرى من حيث الحدة والاعراض و طريقة العلاج.
الدلتا تصير نتيجة انخفاض في انتاج سلاسل الهيموغلوبين و تعويضها بزيادة هيموغلوبين جيني.
الدلتا تصير نتيجة انخفاض في انتاج سلاسل الهيموغلوبين و تعويضها بزيادة هيموغلوبين جيني.
هل يمكن علاج المرض نهائياً ؟
- المرض وراثي و متواجد منذ الولادة في نخاع العظم
- العلاج المتبع هو تخفيف حده المرض
- يوجد علاج آخر وهو استبدال نخاع العظم و يوجد امل كبير على العلاج الجيني 🎗️
- المرض وراثي و متواجد منذ الولادة في نخاع العظم
- العلاج المتبع هو تخفيف حده المرض
- يوجد علاج آخر وهو استبدال نخاع العظم و يوجد امل كبير على العلاج الجيني 🎗️
و بجذي نكون كملنا من ملف الثلاسيميا 🎗️💛
اتمنى انكم استفدتون من المعلومات ✨
و دُمتم سالمين 💛✨
#سكلر_واعي
اتمنى انكم استفدتون من المعلومات ✨
و دُمتم سالمين 💛✨
#سكلر_واعي
جاري تحميل الاقتراحات...